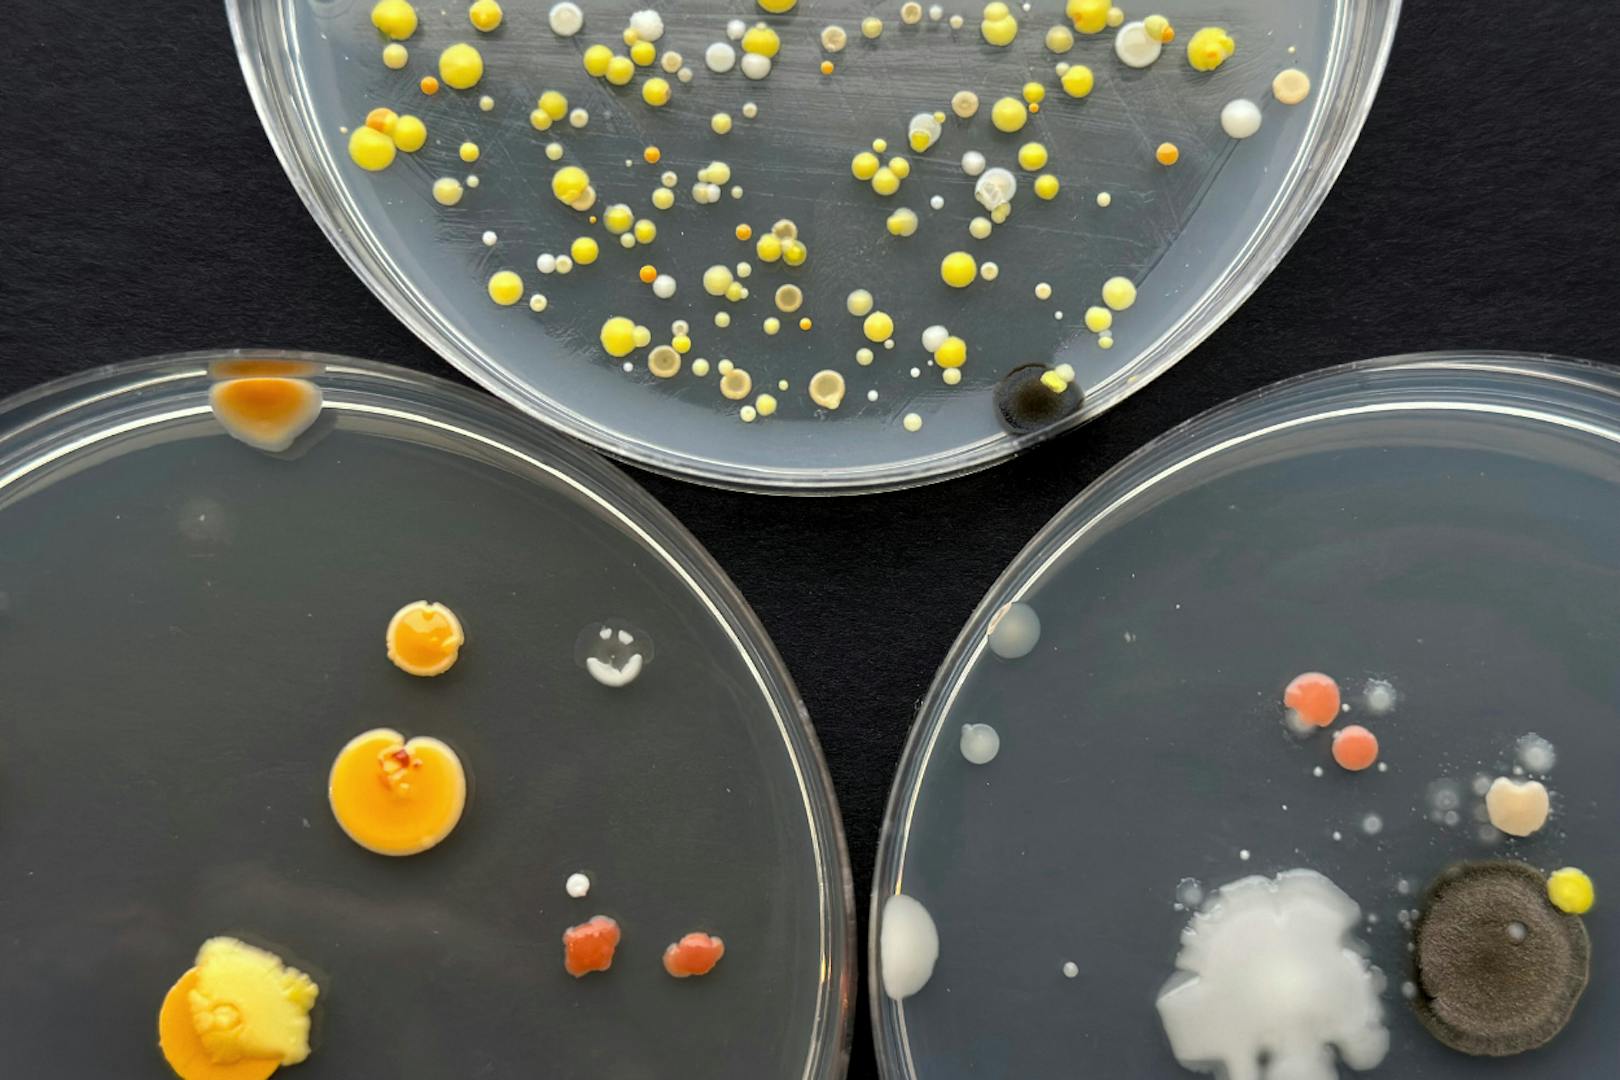

Opnun: Örverur á heimilinu
Föstudaginn 27. september kl 17:00 opnar sýning Örverur á heimilinu í Hönnunarsafni Íslands. Örverur á heimilinu er hluti af sýningarröðinni Heimsókn á Hönnunarsafni Íslands.
Sýningin leiðir gesti í samstarf mannfólks við þessar örsmáu félagsverur, sem er að finna í svo að segja öllum hornum heimilisins. Sýningin beinir kastljósinu að fjölbreyttri örveruflóru sem umlykur og býr innra með fólki, því ólíka samstarfi sem fólk á við örverur í hversdeginum og er ætlað að hvetja það til frekara samstarfs við örverur dags daglega.
Þó heimur örvera sé að mestu hulinn augum þá á fólk engu að síður í margskonar samstarfi við örverur innan sem utan líkamans. Talið er að meðalmanneskjan sé samsett úr um 30 billjónum mannlegra fruma en 38 billjónum örvera. Þannig má segja að mannslíkaminn sé afrakstur af samstarfi ólíkra tegunda. Samstarf við örverur á sér líka stað utan líkamans og teygir sig meðal annars inn á heimili, til dæmis í formi moltugerðar og súrdeigsbaksturs.
Örverur á heimilinu er ein af afurðum þverfaglega rannsóknarverkefnisins Samlífi manna og örvera í daglega lífinu undir stjórn dr. Valdimars Tr. Hafstein. Verkefnið, sem staðið hefur undanfarin þrjú ár, leiðir saman þjóðfræðinga, mannfræðinga, næringarfræðinga og líffræðinga frá Háskóla Íslands og Matís.
Sýningarstjóri er Ragnheiður Maísól Sturludóttir, en sýningarhönnun og textagerð er unnin í samstarfi við Elínu Örnu Kristjánsdóttur og Ingibjörgu Sædísi. Sýningin er einnig unnin í samstarfi við starfsfólk Hönnunarsafns Íslands, Melta, Biopol, Ístex, Textílmiðstöð Íslands, Elin Margot, Matís, Þjóðminjasafnið og Tæknisetrið.
Rannsakendur í Samlífi manna og örvera í daglega lífinu eru Áki G. Karlsson, Birna G. Ásbjörnsdóttir, Bryndís Eva Birgisdóttir, Eysteinn Ari Bragason, Helga Ögmundardóttir, Jón Þór Pétursson, Ragnheiður Maísól Sturludóttir, Sandra Smáradóttir, Signý Guðmundsdóttir, Sigurlaug Skírnisdóttir, Valdimar Tr. Hafstein og Viggó Þór Marteinsson.
Sýningin er styrkt af Rannís, Nýsköpunarsjóði námsmanna og NordForsk.
Í tengslum við sýninguna fer fram performatívan matarviðburð laugardaginn 5. október kl. 16 sem ber yfirskriftina „Það jafnast ekkert á við brauð“ og fimmtudaginn 10. október frá 13-16 verður boðið upp á fyrirlestra, smiðjur og smakk í tengslum við sýninguna.
Sýningin stendur til 17. nóvember
Hönnunarsafn Íslands, Garðatorgi, er opið alla daga frá 12-17 nema mánudaga.


